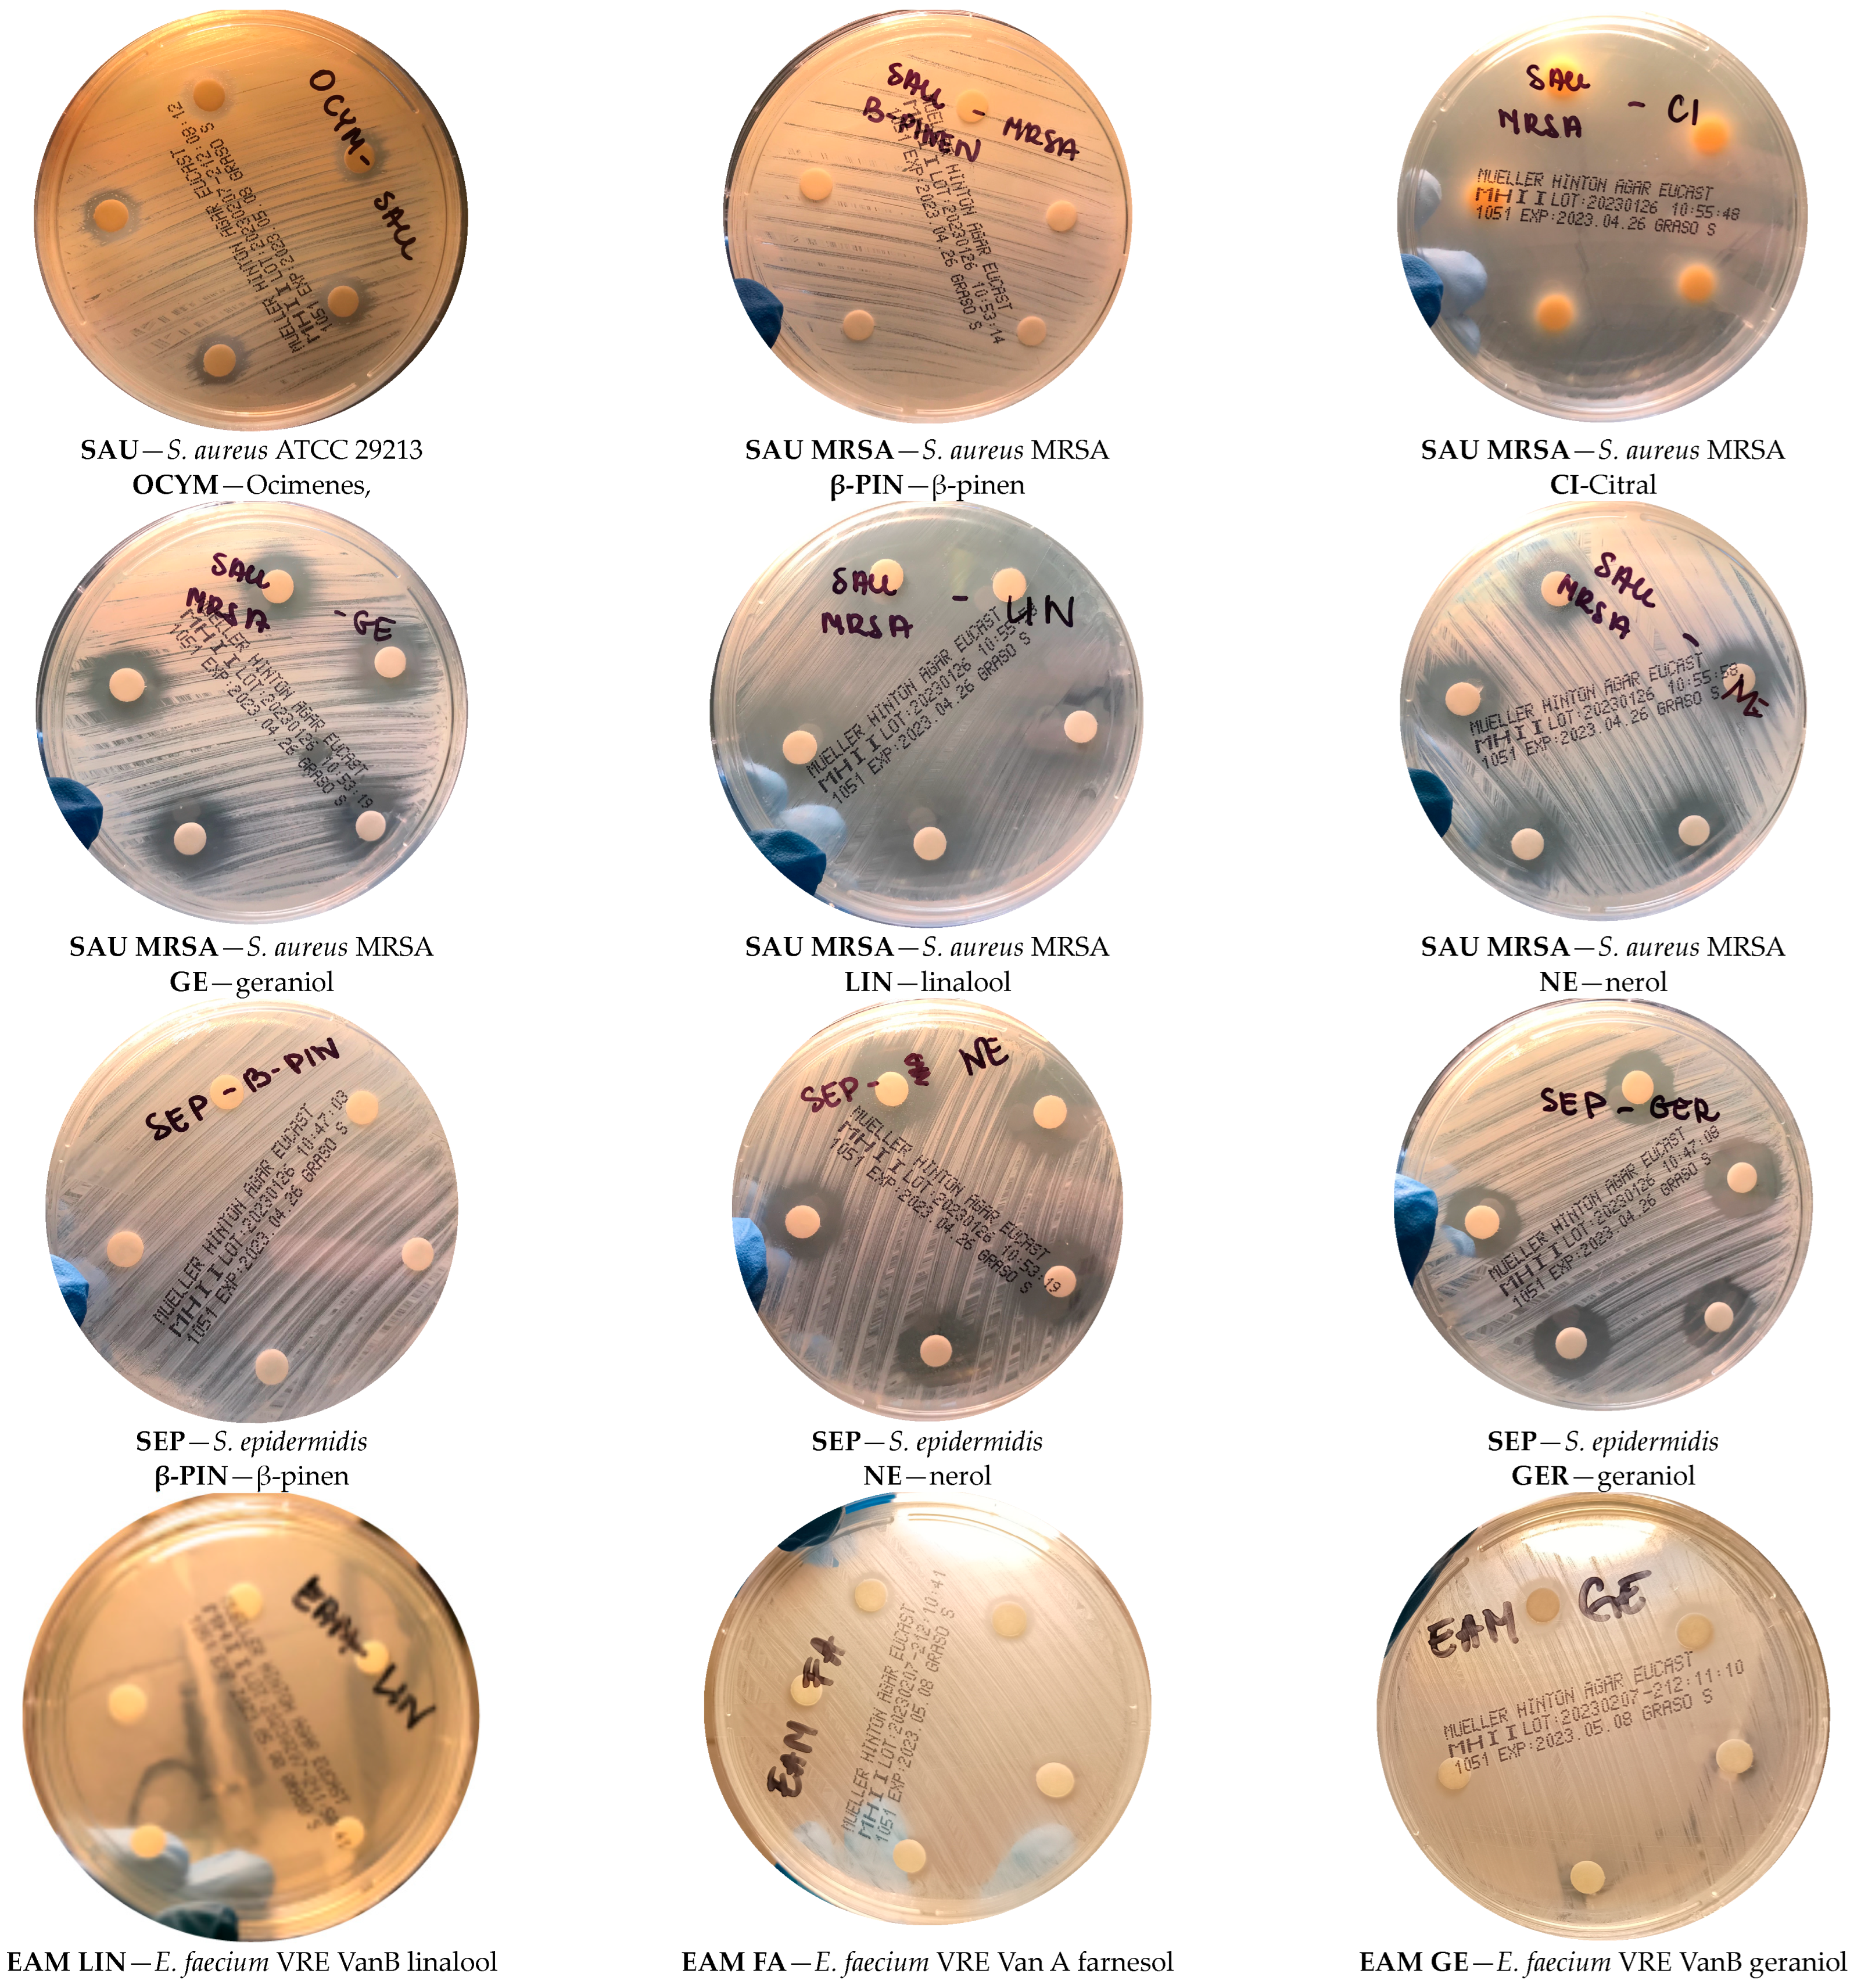
Molecules 29 00950 g009

Evaluation of the Antimicrobial Activity of Geraniol and Selected Geraniol Transformation Products against Gram-Positive Bacteria
Abstract
:1. Introduction
- (1)
- The determination of the antimicrobial activity of geraniol and compounds formed during the transformation of geraniol in relation to selected Gram-positive bacteria (the research concerned pure, individually used compounds) and a preliminary assessment as to whether these compounds can act as ingredients of preparations with potential antimicrobial effects in the treatment of various diseases (skin diseases, digestive system diseases, respiratory system diseases, arthritis, urinary tract infections, and infections of postoperative and post-burn wounds).
- (2)
- The examination of the microbiological purity of cream samples obtained with various contents of geraniol and its transformation products (content of tested compounds: 0.5%, 1%, 2.5%, 4%, 8%, and 12%) and an assessment, based on the results obtained, as to whether these compounds show preservative properties in prepared cream samples, thereby reducing the risk of the development of microorganisms, causing a reduction in the quality of cosmetic products.
2. Results and Discussion
2.1. Antibacterial Activity of Geraniol and Products of Its Transformation
2.2. Microbiological Stability of Creams with Geraniol and Products of Its Transformation
3. Materials and Methods
3.1. Raw Materials, Cream Base, and Microbiological Media
3.2. Microorganisms and Inoculum
3.3. Antibacterial Activity of Geraniol and Products of Its Transformation
3.4. Preparation of Creams with Geraniol and Products of Its Transformation
3.5. Microbiological Stability of Creams with Geraniol and Products of Its Transformation
4. Conclusions
Author Contributions
Funding
Institutional Review Board Statement
Informed Consent Statement
Data Availability Statement
Conflicts of Interest
References
- Mohd-Setapar, S.M.; John, C.P.; Mohd-Nasir, H.; Mohsin Azim, M.; Ahmad, A.; Alshammari, M. Application of Nanotechnology Incorporated with Natural Ingredients in Natural Cosmetics. Cosmetics 2022, 9, 110. [Google Scholar] [CrossRef]
- Rubinowska, K. Naturalne surowce pochodzenia roślinnego w kosmetykach do makijażu, od starożytności do współczesności. In Wybrane Aspekty Biokosmetologii; Wydawnictwo Uniwersytetu Przyrodniczego w Lublinie, Ark: Lublin, Poland, 2021; pp. 9–21. [Google Scholar]
- Adaszyńska, M.; Swarcewicz, M. Essential oils as an active ingredients or preservativies in cosmetics. Wiadomościchemiczne 2012, 66, 140–158. [Google Scholar]
- Sulborska-Różycka, A.; Masierowska, M. Wykorzystanie Produktów Pszczelich w Kosmetologii, Wybrane Aspekty Biokosmetologii; Wydawnictwo Uniwersytetu Przyrodniczego w Lublinie, Ark: Lublin, Poland, 2021; pp. 178–214. [Google Scholar]
- Kusumawati, I.; Indrayanto, G. “Natural Antioxidants in Cosmetics” Studies in Natural Products. Chemistry 2013, 15, 486–505. [Google Scholar]
- Halliwell, L. Free radicals, antioxidants and human diseases: Curiosity, cause, or consequence? Lancet 1994, 344, 721–724. [Google Scholar] [CrossRef] [PubMed]
- Deska, M.; Girek, T.; Herman, B. Środki Konserwujące w Preparatach Kosmetycznych i Bezpieczenństwo ich Stosowania; Publishing house of the Jan Długosz University of Humanities and Sciences in Częstochowa: Częstochowa, Poland, 2016; pp. 87–108. [Google Scholar]
- Kaniewski, R.; Pniewska, I.; Świejkowski, M. Możliwości wykorzystania olejków eterycznych, ze szczególnym uwzględnieniem olejku konopnego, jako substancji aktywnych i środków konserwujących kosmetyki. Post Fitoter. 2016, 17, 125–129. [Google Scholar]
- Mondéjar-López, M.; López-Jimenez, A.; Martínez, J.; Ahrazem, O.; Gómez-Gómez, L. Comparative evaluation of carvacrol and eugenol chitosan nanoparticles as eco-friendly preservative agents in cosmetics. Int. J. Biol. Macromol. 2022, 206, 288–297. [Google Scholar] [CrossRef] [PubMed]
- Karuppayil, R. A status review on the medicinal properties of essential oils. Ind. Crops Prod. 2014, 62, 250–264. [Google Scholar]
- Król, S.; Skalicka-Woźniak, K.; Kandefer-Szerszeń, M.; Stepulak, A. Aktywność biologiczna i farmakologiczna olejków eterycznych w leczeniu i profilaktyce chorób infekcyjnych. Postep. Hig. Med. Doświadczalnej 2013, 67, 1000–1007. [Google Scholar] [CrossRef]
- Nazzaro, F.; Fratianni, F.; De Martino, L.; Coppola, R.; De Feo, V. Effect of Essential Oils on Pathogenic Bacteria. Pharmaceuticals 2013, 6, 1451–1474. [Google Scholar] [CrossRef]
- Saad, N.Y.; Muller, C.D.; Lobstein, A. Major bioactivities and mechanism of action of essential oils and their components. Flavour. Fragr. J. 2013, 28, 269–279. [Google Scholar] [CrossRef]
- Tetali, S.D. Terpenes and isoprenoids: A wealth of compounds for global use. Planta 2019, 249, 1–8. [Google Scholar] [CrossRef]
- Hadian, Z.; Maleki, M.; Feizollahi, E.; Alibeyk, S.; Saryazdi, M. Health aspects of geraniol as a main bioactive compound of Rosa damascena Mill: A systematic review. Electron. Phys. 2020, 12, 7724–7735. [Google Scholar] [CrossRef] [PubMed]
- Weiyang, C.; Viljoen, A. Geraniol—A review of a commercially important fragrance material. S. Afr. J. Bot. 2010, 76, 643–651. [Google Scholar]
- Wróblewska, A.; Fajdek-Bieda, A.; Markowska-Szczupak, A.; Radkowska, M. Preliminary microbiological tests of s-carvone and geraniol and selected derivatives of these compounds that may be formed in the processes of isomerization and oxidation. Molecules 2022, 27, 7012. [Google Scholar] [CrossRef] [PubMed]
- Minsoo, C. The antitumor effects of geraniol: Modulation of cancer hallmark pathways. Int. J. Oncol. 2016, 48, 1772–1782. [Google Scholar]
- Kareem, D. Antimicrobial activity of cinnamaldehyde or geraniol alone or combined with high pressure processing to destroy Escherichia coli O157: H7 and Salmonella enterica in juices. Doctoral Dissertation, Iowa State University, Ames, IA, USA, 2016. [Google Scholar]
- Lin, L. The inhibitory efficiencies of geraniol as an anti-inflammatory, antioxidant, and antibacterial, natural agent against methicillin-resistant Staphylococcus aureus infection in vivo. Infect. Drug Resist. 2021, 14, 2991–3000. [Google Scholar] [CrossRef] [PubMed]
- Leite, M. Investigating the antifungal activity and mechanism (s) of geraniol against Candida albicans strains. Med. Mycol. 2015, 53, 275–284. [Google Scholar] [CrossRef] [PubMed]
- Shankar, R.; Mohan Karuppayil, S. Phytochemicals as inhibitors of Candida biofilm. Curr. Pharm. Des. 2016, 22, 4111–4134. [Google Scholar] [CrossRef]
- Zeynep, A. Electrospinning of polymer-free cyclodextrin/geraniol–inclusion complex nanofibers: Enhanced shelf-life of geraniol with antibacterial and antioxidant properties. RSC Adv. 2016, 6, 46089–46099. [Google Scholar]
- Rebai, B. Potential Effects of Geraniol on Cancer and Inflammation-Related Diseases: A Review of the Recent Research Findings. Molecules 2023, 28, 3669. [Google Scholar]
- Mączka, W.; Wińska, K.; Grabarczyk, M. One hundred faces of geraniol. Molecules 2020, 25, 3303. [Google Scholar] [CrossRef] [PubMed]
- Retajczyk, M.; Wróblewska, A.; Szymańska, A.; Miądlicki, P.; Koren, C.; Michalkiewicz, B. Synthesis, Characterization, and catalytic applications of the Ti-SBA-16 porous material in the selective and green isomerizations of limonene and S-carvone. Catalysts 2020, 10, 1452. [Google Scholar] [CrossRef]
- Kittler, J. Content and composition of essential oil and content of rosmarinic acid in lemon balm and balm genotypes (Melissa officinalis). Genet. Resour. Crop Evol. 2018, 65, 1517–1527. [Google Scholar] [CrossRef]
- Surburg, H.; Panten, J. Common Fragrance and Flavor Materials: Preparation, Properties and Uses; John Wiley & Sons: Hoboken, NJ, USA, 2016. [Google Scholar]
- Atolani, O. Chemical composition, antioxidant, anti-lipooxygenase, antimicrobial, anti-parasite and cytotoxic activities of P olyalthia longifolia seed oil. Med. Chem. Res. 2019, 28, 515–527. [Google Scholar] [CrossRef]
- Egbuna, C. Phytochemistry: Volume 1: Fundamentals, Modern Techniques, and Applications; CRC Press: Boca Raton, FL, USA, 2018. [Google Scholar]
- Nishijima, C. Citral: A monoterpene with prophylactic and therapeutic anti-nociceptive effects in experimental models of acute and chronic pain. Eur. J. Pharmacol. 2014, 736, 16–25. [Google Scholar] [CrossRef] [PubMed]
- Périco, L. Systematic analysis of monoterpenes: Advances and challenges in the treatment of peptic ulcer diseases. Biomolecules 2020, 10, 265. [Google Scholar] [CrossRef] [PubMed]
- Bouzenna, H.; Hfaiedh, N.; Giroux-Metges, M.A.; Elfeki, A.; Talarmin, H. Biological properties of citral and its potential protective effects against cytotoxicity caused by aspirin in the IEC-6 cells. Biomed. Pharmacother. 2017, 87, 653–660. [Google Scholar] [CrossRef] [PubMed]
- Espina, L.; Berdejo, D.; Alfonso, P.; García-Gonzalo, D.; Pagán, R. Potential use of carvacrol and citral to inactivate biofilm cells and eliminate biofouling. Food Control 2017, 82, 256–265. [Google Scholar] [CrossRef]
- Kuwahara, Y.; Suzuki, H.; Matsumoto, K. Pheromone study on acarid mites. XI. Function of mite body as geometrical isomerization and reduction of citral (the alarm pheromone) Carpoglyphus lactis. Appl. Entomol. Zool. 1983, 18, 30–39. [Google Scholar] [CrossRef]
- Bouzenna, H.; Hfaiedh, N.; Giroux-Metges, M.A.; Elfeki, A.; Talarmin, H. Protective effects of essential oil of Citrus limon against aspirin-induced toxicity in IEC-6 cells. Appl. Physiol. Nutr. Metab. 2017, 42, 479–486. [Google Scholar] [CrossRef]
- Pucci, M.; Raimondo, S.; Zichittella, C.; Tinnirello, V.; Corleone, V.; Aiello, G.; Moschetti, M.; Conigliaro, A.; Fontana, S.; Alessandro, R. Biological properties of a citral-enriched fraction of Citrus limon essential oil. Foods 2020, 9, 1290. [Google Scholar] [CrossRef] [PubMed]
- Yuxiang, Z.; Wei, J.; Chen, H.; Song, Z.; Guo, H.; Yuan, Y.; Yue, T. Antibacterial activity of essential oils against Stenotrophomonas maltophilia and the effect of citral on cell membrane. LWT 2020, 117, 108667–108671. [Google Scholar]
- Kang, S.; Li, X.; Xing, Z.; Liu, X.; Bai, X.; Yang, Y.; Guo, D.; Xia, X.; Zhang, C.; Shi, C. Antibacterial effect of citral on yersinia enterocolitica and its mechanism. Food Control 2022, 35, 108775–108779. [Google Scholar] [CrossRef]
- Cai, R.; Hu, M.; Zhang, Y.; Niu, C.; Yue, T.; Yuan, Y.; Wang, Z. Antifungal activity and mechanism of citral, limonene and eugenol against Zygosaccharomyces rouxii. LWT 2019, 106, 50–56. [Google Scholar] [CrossRef]
- Vespermann, K. Biotransformation of α-and β-pinene into flavor compounds. Appl. Microbiol. Biotechnol. 2017, 101, 1805–1817. [Google Scholar] [CrossRef]
- Aristides Medeiros, L. Inhibitory effect of beta-pinene, alpha-pinene and eugenol on the growth of potential infectious endocarditis causing Gram-positive bacteria. Rev. Bras. Ciências Farm. 2007, 43, 121–126. [Google Scholar]
- Lopes, P. Biological Activities of a-Pinene and [beta]-Pinene Enantiomers. Molecules 2012, 17, 6305. [Google Scholar]
- Krom, B.P.; Cohen, J.B.; Feser, G.E.M.; Cihlar, R.L. Optimized candidal biofilm microtiter assay. J. Microbiol. Methods 2007, 6, 421–423. [Google Scholar] [CrossRef] [PubMed]
- Mosmann, T. Rapid colorimetric assay for cellular growth and survival: Application to proliferation and cytotoxicity assays. J. Immunol. Methods 1983, 65, 55–63. [Google Scholar] [CrossRef]
- Schoofs, A.; Odds, F.C.; Colebunders, R.; Leven, M.; Goussens, H. Use of specialized isolation media for recognition and identification of Candida dubliniensis isolates from HIV infected patients. Eur. J. Clin. Microbiol. Infect. Dis. 1997, 16, 296–300. [Google Scholar] [CrossRef]
- Holt, S. The molecular biology of fruity and floral aromas in beer and other alcoholic beverages. FEMS Microbiol. Rev. 2019, 43, 193–222. [Google Scholar] [CrossRef]
- Lapczynski, A.; Foxenberg, R.J.; Bhatia, S.P.; Letizia, C.S.; Api, A.M. Fragrance material review on nerol. Food Chem. Toxicol. 2008, 46, 241–244. [Google Scholar] [CrossRef]
- Costa Marques, T.H.; Leonildes, B.; Gomes, C.; Branco Marques, M.; dos Santos Lima, D.; Santos Siqueira, H.D.; Damasceno Nogueira Neto, J.; do Socorro Boavista Gomes Castelo Branco, M.; Araújo de Souza, A.; Pergentino de Sousa, D.; et al. Evaluation of the neuropharmacological properties of nerol in mice. World J. Neurosci. 2013, 3, 32–38. [Google Scholar] [CrossRef]
- Ammar, A.H.; Bouajila, J.; Lebrihi, A.; Mathieu, F.; Romdhane, M.; Zagrouba, F. Chemical composition and in vitro antimicrobial and antioxidant activities of Citrus aurantium L. flowers essential oil (Neroli oil). Pak. J. Biol. Sci. 2012, 2, 1034–1040. [Google Scholar] [CrossRef]
- Consolini, A.E.; Berardi, A.; Rosella, M.A.; Volonté, M. Antispasmodic effects of Aloysia polystachya and A. gratissima tinctures and extracts are due to non- competitive inhibition of intestinal contractility induced by acethylcholine and calcium. Rev. Bras. Farmacogn. 2011, 21, 889–900. [Google Scholar] [CrossRef]
- Ali, B. Essential oils used in aromatherapy: A systemic review. Asian Pac. J. Trop. Biomed. 2015, 5, 601–611. [Google Scholar] [CrossRef]
- Wilson, R. Aromatherapy: Essential Oils for Vibrant Health and Beauty; Penguin Publishing: London, UK, 2002; ISBN 9781583331309. [Google Scholar]
- Perry, N.; Perry, E. Aromatherapy in the management of psychiatric disorders: Clinical and neuropharmacological perspectives. CNS Drugs 2006, 20, 257–280. [Google Scholar] [CrossRef]
- Derengowski, L.S.; De-Souza-Silva, C.; Braz, S.V.; Mello-De-Sousa, T.M.; Báo, S.N.; Kyaw, C.M.; Silva-Pereira, I. Antimicrobial effect of farnesol, a Candida albicans quorum sensing molecule, on Paracoccidioides brasiliensis growth and morphogenesis. Ann. Clin. Microbiol. Antimicrob. 2009, 8, 13. [Google Scholar] [CrossRef]
- Abuohashish, H.M.; Al-Rejaie, S.S.; Al-Hosaini, K.A.; Parmar, M.Y.; Ahmed, M.M. Alleviating effects of morin against experimentally-induced diabetic. Osteopenia. Diabetol. Metab. Syndr. 2013, 5, 5. [Google Scholar] [CrossRef] [PubMed]
- Polke, M.; Jacobsen, I.D. Quorum sensing by farnesol revisited. Curr Genet. 2017, 63, 791–797. [Google Scholar] [CrossRef]
- Jabra-Rizk, M.A. Effect of farnesol on Staphylococcus aureus biofilm formation and antimicrobial susceptibility. Antimicrob. Agents Chemother. 2006, 50, 1463–1469. [Google Scholar] [CrossRef]
- de Araújo Delmondes, G. Toxicological and pharmacologic effects of farnesol (C15H26O): A descriptive systematic review. Food Chem. Toxicol. 2019, 129, 169–200. [Google Scholar] [CrossRef]
- Yamada, A.N.; Grespan, R.; Yamada, A.T.; Silva, E.L.; Silva-Filho, S.E.; Damiao, M.J.; de Oliveira Dalalio, M.M.; Bersani-Amado, C.A. Anti-inflammatory activity of Ocimumamericanum L. essential oil in experimental model of zymosan-induced arthritis. Am. J. Chin. Med. 2013, 41, 913–926. [Google Scholar] [CrossRef] [PubMed]
- Djenane, D.; Aider, M.; Yanguela, J.; Idir, L. Antioxidant and antibacterial effects of Lavandula and Mentha essential oils in minced beef inoculated with E. coli O157:H7 and S. aureus during storage at abuse refrigeration temperature. Meat. Sci. 2012, 92, 667–674. [Google Scholar] [CrossRef] [PubMed]
- Quintans-Junior, L.J.; Barreto, R.S.; Menezes, P.P.; Almeida, J.R. β-Cyclodextrin-complexed (-)-linalool produces antinociceptive effect superior to that of (-)-linalool in experimental pain protocols. Basic Clin. Pharmacol. Toxicol. 2013, 113, 167–172. [Google Scholar] [CrossRef] [PubMed]
- Phillips, C.A.; Gkatzionis, K.; Laird, K.; Score, J. Identification and quantification of the antimicrobial components of a citrus essential oil vapor. Nat. Prod. Commun. 2012, 7, 103–107. [Google Scholar] [CrossRef] [PubMed]
- Aprotosoaie, A.C.; Hancianu, M.; Costacheb, I.I.; Mirona, A. Linalool: A review on a key odorant molecule with valuable biological properties. Flavour Fragr. J. 2014, 29, 193–219. [Google Scholar] [CrossRef]
- Kamatou, G.P.; Viljoen, A.M. Linalool—A review of a biologically active compound of commercial importance. Nat. Prod. Commun. 2008, 3, 1183–1192. [Google Scholar] [CrossRef]
- Sharma, M. Assessment of the Impact of Herbal Drugs Used in Neurodegenerative Disorders: A Preclinical Review. Curr. Tradit. Med. 2022, 8, 39–49. [Google Scholar]
- Gakuubi, M. Evaluation of Yield, Chemical Composition and Antimicrobial Activity of Essential Oils of Tagetes minuta L. (Asteraceae) Against Selected Phytopathogens. Ph.D. Thesis, University of Nairobi-Catholic University of Eastern Africa, Nairobi, Kenya, 2016. [Google Scholar]
- Diniz do Nascimento, L. Bioactive natural compounds and antioxidant activity of essential oils from spice plants: New findings and potential applications. Biomolecules 2020, 10, 988. [Google Scholar] [CrossRef]
- Maggini, S. Feeding the immune system: The role of micronutrients in restoring resistance to infections. CABI Rev. 2008, 1–21. [Google Scholar] [CrossRef]
- Shirazi, M.T.; Gholami, H.; Kavoosi, G.; Rowshan, V.; Tafsiry, A. Chemical composition, antioxidant, antimicrobial and cytotoxic activities of T. agetesminuta and O. cimumbasilicum essential oils. Food Sci. Nutr. 2014, 2, 146–155. [Google Scholar] [CrossRef]
- Patne, T.; Jayashri, M.; Pranali, T. Inhalation of essential oils: Could be adjuvant therapeutic strategy for COVID-19. Int. J. Pharm. Sci. Res. 2020, 11, 4095–4103. [Google Scholar]
- Maggi, F.; Benelli, G. Essential oils from aromatic and medicinal plants as effective weapons against mosquito vectors of public health importance. In Mosquito-Borne Diseases; Springer: Cham, Switzerland, 2018; pp. 69–129. [Google Scholar] [CrossRef]
- Lubbe, A.; Verpoorte, R. Cultivation of medicinal and aromatic plants for specialty industrial materials. Ind. Crops Prod. 2011, 34, 785–801. [Google Scholar] [CrossRef]
- Yorgancioglu, A.; Bayramoglu, E.E. Production of cosmetic purpose collagen containing antimicrobial emulsion with certain essential oils. Ind. Crops Prod. 2013, 44, 378–382. [Google Scholar] [CrossRef]
- Adwan, G.; Salameh, Y.; Adwan, K. Assessment of antifungal activity of herbal and conventional toothpastes against clinical isolates of Candida albicans. Asian Pac. J. Trop. Biomed. 2012, 2, 375–379. [Google Scholar] [CrossRef]
- Mukherjee, P.K.; Maity, N.; Nema, N.K.; Sarkar, B.K. Bioactive compounds from natural resources against skin aging. Phytomedicine 2011, 19, 64–73. [Google Scholar] [CrossRef] [PubMed]
- Godfrey, D. Healing with Essential Oils: The Antiviral, Restorative, and Life-Enhancing Properties of 58 Plants; Simon and Schuster: New York, NY, USA, 2022. [Google Scholar]
- Lall, N.; Kishore, N. Are plants used for skin care in South Africa fully explored? J. Ethnopharmacol. 2014, 153, 61–84. [Google Scholar] [CrossRef]
- Guzmán, E.; Lucia, A. Essential oils and their individual components in cosmetic products. Cosmetics 2021, 8, 114. [Google Scholar] [CrossRef]
- Pérez, G. Anti-inflammatory activity of some essential oils. J. Essent. Oil Res. 2011, 23, 38–44. [Google Scholar] [CrossRef]
- Dubey, R.; Shami, T.C.; Rao, K.B. Microencapsulation technology and applications. Def. Sci. J. 2009, 59, 82–95. [Google Scholar]
- Adaszyńska, M.; Swarcewicz, M. Olejki eteryczne jako substancje aktywne lub konserwanty w kosmetykach. Wiadomości Chem. 2012, 66, 139–158. [Google Scholar]
- Oliveira, D.; Borges, A.; Simões, M. Staphylococcus aureus toxins and their molecular activity in infectious diseases. Toxins 2018, 10, 252. [Google Scholar] [CrossRef] [PubMed]
- Compton, G.A. Bacterial skin and soft tissue infections in older adults. Clin. Geriatr. Med. 2013, 29, 443–459. [Google Scholar] [CrossRef] [PubMed]
- Carović-stanko, K. Composition and antibacterial activities of essential oils of seven Ocimum taxa. Food Chem. 2010, 119, 196–201. [Google Scholar] [CrossRef]
- Griffin, S.G.; Wyllie, S.G.; Markham, J.L.; Leach, D.N. The role of structure and molecular properties of terpenoids in determining their antimicrobial activity. Flavour. Fragr. J. 1999, 14, 322–332. [Google Scholar] [CrossRef]
- Zengin, H.; Baysal, A. Antibacterial and antioxidant activity of essential oil terpenes against pathogenic and spoilage-forming bacteria and cell structure-activity relationships evaluated by SEM microscopy. Molecules 2014, 11, 17773–17798. [Google Scholar] [CrossRef]
- Chen, J.; Jiang, Q.D.; Chai, Y.P.; Zhang, H.; Peng, P.; Yang, X.X. Natural terpenes as penetration enhancers for transdermal drug delivery. Molecules 2016, 12, 1709. [Google Scholar] [CrossRef]

| Compound/Bacteria | Zones of Inhibition [mm + SD] | ||||||
|---|---|---|---|---|---|---|---|
| S. aureus ATCC 29213 | S. aureus MRSA | S. epidermidis MRSE | E. faecalis ATCC 29212 | E. faecalis VRE VanB | E. faecium VRE VanA | E. faecium VRE VanB | |
| [mm] | [mm] | [mm] | [mm] | [mm] | [mm] | [mm] | |
| Control negative (0.9% NaCl) | 6 ± 0 | 6 ± 0 | 6 ± 0 | 6 ± 0 | 6 ± 0 | 6 ± 0 | 6 ± 0 |
| Control positive (70% ethanol) | 15 ± 0 | 14 ± 0 | 15 ± 0 | 13 ± 0 | 13 ± 0 | 13 ± 0 | 13 ± 0 |
| Geraniol (GE) | 11 ± 0 | 17.4 ± 0.5 | 17.4 ± 0.5 | 6 ± 0 | 9.8 ± 0.4 | 20.2 ± 0.4 | 12 ± 0 |
| Citral (CI) | 39.6 ± 0.5 | 20 ± 0 | 42.6 ± 0.5 | 36.8 ± 0.8 | 14.6 ± 0.5 | 40 ± 0 | 39.6 ± 0.5 |
| β-pinene (BP) | 6 ± 0 | 6 ± 0 | 6 ± 0 | 6 ± 0 | 6 ± 0 | 6 ± 0 | 6 ± 0 |
| Nerol (NE) | 12.4 ± 0.5 | 15.6 ± 0.5 | 18.6 ± 0.5 | 9.8 ± 0.4 | 11.4 ± 0.5 | 16.2 ± 0.4 | 16.2 ± 0.4 |
| Farnesol (FA) | 6 ± 0 | 6 ± 0 | 6 ± 0 | 6 ± 0 | 6 ± 0 | 10 ± 0 | 10 ± 0 |
| Linalool (LI) | 40 ± 0 | 23.6 ± 0.5 | 30 ± 0 | 23.8 ± 0.4 | 25 ± 0 | 14 ± 0 | 37.8 ± 0.4 |
| Ocimenes (OC) | 12 ± 0 | 10 ± 0 | 10 ± 0 | 15.4 ± 0.5 | 10 ± 0 | 12 ± 0 | 9.8 ± 0.4 |
| the diameter of the sterile disc was 6 mm | |||||||
| CREAM BASE + COMPOUND | PCA | MC | MSA | |
|---|---|---|---|---|
| Cream base (BZ) | 0 CFU/mL | 0 CFU/mL | 0 CFU/mL | |
| Geraniol (GE) | 0.5% | 0 CFU/mL | 0 CFU/mL | 0 CFU/mL |
| 1.5% | 0 CFU/mL | 0 CFU/mL | 0 CFU/mL | |
| 2.5% | 0 CFU/mL | 0 CFU/mL | 0 CFU/mL | |
| 4% | 0 CFU/mL | 0 CFU/mL | 0 CFU/mL | |
| 8% | 0 CFU/mL | 0 CFU/mL | 0 CFU/mL | |
| 12% | 0 CFU/mL | 0 CFU/mL | 0 CFU/mL | |
| Citral (CI) | 0.5% | 0 CFU/mL | 0 CFU/mL | 0 CFU/mL |
| 1.5% | 0 CFU/mL | 0 CFU/mL | 0 CFU/mL | |
| 2.5% | 0 CFU/mL | 0 CFU/mL | 0 CFU/mL | |
| 4% | 0 CFU/mL | 0 CFU/mL | 0 CFU/mL | |
| 8% | 0 CFU/mL | 0 CFU/mL | 0 CFU/mL | |
| 12% | 0 CFU/mL | 0 CFU/mL | 0 CFU/mL | |
| β-pinen (BP) | 0.5% | 0 CFU/mL | 0 CFU/mL | 0 CFU/mL |
| 1.5% | 0 CFU/mL | 0 CFU/mL | 0 CFU/mL | |
| 2.5% | 0 CFU/mL | 0 CFU/mL | 0 CFU/mL | |
| 4% | 0 CFU/mL | 0 CFU/mL | 0 CFU/mL | |
| 8% | 0 CFU/mL | 0 CFU/mL | 0 CFU/mL | |
| 12% | 0 CFU/mL | 0 CFU/mL | 0 CFU/mL | |
| Nerol (NE) | 0.5% | 0 CFU/mL | 0 CFU/mL | 0 CFU/mL |
| 1.5% | 0 CFU/mL | 0 CFU/mL | 0 CFU/mL | |
| 2.5% | 0 CFU/mL | 0 CFU/mL | 0 CFU/mL | |
| 4% | 0 CFU/mL | 0 CFU/mL | 0 CFU/mL | |
| 8% | 0 CFU/mL | 0 CFU/mL | 0 CFU/mL | |
| 12% | 0 CFU/mL | 0 CFU/mL | 0 CFU/mL | |
| Linalool (LI) | 0.5% | 0 CFU/mL | 0 CFU/mL | 0 CFU/mL |
| 1.5% | 0 CFU/mL | 0 CFU/mL | 0 CFU/mL | |
| 2.5% | 0 CFU/mL | 0 CFU/mL | 0 CFU/mL | |
| 4% | 0 CFU/mL | 0 CFU/mL | 0 CFU/mL | |
| 8% | 0 CFU/mL | 0 CFU/mL | 0 CFU/mL | |
| 12% | 0 CFU/mL | 0 CFU/mL | 0 CFU/mL | |
| Farnesol (FA) | 0.5% | 0 CFU/mL | 0 CFU/mL | 0 CFU/mL |
| 1.5% | 0 CFU/mL | 0 CFU/mL | 0 CFU/mL | |
| 2.5% | 0 CFU/mL | 0 CFU/mL | 0 CFU/mL | |
| 4% | 0 CFU/mL | 0 CFU/mL | 0 CFU/mL | |
| 8% | 0 CFU/mL | 0 CFU/mL | 0 CFU/mL | |
| 12% | 0 CFU/mL | 0 CFU/mL | 0 CFU/mL | |
| Ocimenes (OC) | 0.5% | 0 CFU/mL | 0 CFU/mL | 0 CFU/mL |
| 1.5% | 0 CFU/mL | 0 CFU/mL | 0 CFU/mL | |
| 2.5% | 0 CFU/mL | 0 CFU/mL | 0 CFU/mL | |
| 4% | 0 CFU/mL | 0 CFU/mL | 0 CFU/mL | |
| 8% | 0 CFU/mL | 0 CFU/mL | 0 CFU/mL | |
| 12% | 0 CFU/mL | 0 CFU/mL | 0 CFU/mL | |
| CREAM BASE + COMPOUND | BHI Broth | D/E Neutralizing Broth | |
|---|---|---|---|
| Cream base (BZ) | 0 CFU/mL | 0 CFU/mL | |
| Geraniol (GE) | 0.5% | 0 CFU/mL | 0 CFU/mL |
| 1.5% | 0 CFU/mL | 0 CFU/mL | |
| 2.5% | 0 CFU/mL | 0 CFU/mL | |
| 4% | 0 CFU/mL | 0 CFU/mL | |
| 8% | 0 CFU/mL | 0 CFU/mL | |
| 12% | 0 CFU/mL | 0 CFU/mL | |
| Citral (CI) | 0.5% | 0 CFU/mL | 0 CFU/mL |
| 1.5% | 0 CFU/mL | 0 CFU/mL | |
| 2.5% | 0 CFU/mL | 0 CFU/mL | |
| 4% | 0 CFU/mL | 0 CFU/mL | |
| 8% | 0 CFU/mL | 0 CFU/mL | |
| 12% | 0 CFU/mL | 0 CFU/mL | |
| β-pinen (BP) | 0.5% | 0 CFU/mL | 0 CFU/mL |
| 1.5% | 0 CFU/mL | 0 CFU/mL | |
| 2.5% | 0 CFU/mL | 0 CFU/mL | |
| 4% | 0 CFU/mL | 0 CFU/mL | |
| 8% | 0 CFU/mL | 0 CFU/mL | |
| 12% | 0 CFU/mL | 0 CFU/mL | |
| Nerol (NE) | 0.5% | 0 CFU/mL | 0 CFU/mL |
| 1.5% | 0 CFU/mL | 0 CFU/mL | |
| 2.5% | 0 CFU/mL | 0 CFU/mL | |
| 4% | 0 CFU/mL | 0 CFU/mL | |
| 8% | 0 CFU/mL | 0 CFU/mL | |
| 12% | 0 CFU/mL | 0 CFU/mL | |
| Linalool (LI) | 0.5% | 0 CFU/mL | 0 CFU/mL |
| 1.5% | 0 CFU/mL | 0 CFU/mL | |
| 2.5% | 0 CFU/mL | 0 CFU/mL | |
| 4% | 0 CFU/mL | 0 CFU/mL | |
| 8% | 0 CFU/mL | 0 CFU/mL | |
| 12% | 0 CFU/mL | 0 CFU/mL | |
| Farnesol (FA) | 0.5% | 0 CFU/mL | 0 CFU/mL |
| 1.5% | 0 CFU/mL | 0 CFU/mL | |
| 2.5% | 0 CFU/mL | 0 CFU/mL | |
| 4% | 0 CFU/mL | 0 CFU/mL | |
| 8% | 0 CFU/mL | 0 CFU/mL | |
| 12% | 0 CFU/mL | 0 CFU/mL | |
| Ocimenes (OC) | 0.5% | 0 CFU/mL | 0 CFU/mL |
| 1.5% | 0 CFU/mL | 0 CFU/mL | |
| 2.5% | 0 CFU/mL | 0 CFU/mL | |
| 4% | 0 CFU/mL | 0 CFU/mL | |
| 8% | 0 CFU/mL | 0 CFU/mL | |
| 12% | 0 CFU/mL | 0 CFU/mL | |
| Concentration | 0.5% | 1.5% | 2.5% | 4% | 8% | 12% |
|---|---|---|---|---|---|---|
| mg/mL | mg/mL | mg/mL | mg/mL | mg/mL | mg/mL | |
| Geraniol (GE) | 4.45 | 13.35 | 22.25 | 35.6 | 71.2 | 106.8 |
| Citral (CI) | 4.45 | 13.35 | 22.25 | 35.6 | 71.2 | 106.8 |
| β-pinene (BP) | 4.3 | 12.9 | 21.5 | 34.4 | 68.8 | 103.2 |
| Nerol (NE) | 4.45 | 13.35 | 22.25 | 35.6 | 71.2 | 106.8 |
| Farnesol (FA) | 4.45 | 13.35 | 22.25 | 35.6 | 71.2 | 106.8 |
| Linalool (LI) | 4.3 | 12.9 | 21.5 | 34.4 | 68.8 | 103.2 |
| Ocimenes (OC) | 4.3 | 12.9 | 21.5 | 34.4 | 68.8 | 103.2 |
Disclaimer/Publisher’s Note: The statements, opinions and data contained in all publications are solely those of the individual author(s) and contributor(s) and not of MDPI and/or the editor(s). MDPI and/or the editor(s) disclaim responsibility for any injury to people or property resulting from any ideas, methods, instructions or products referred to in the content. |
© 2024 by the authors. Licensee MDPI, Basel, Switzerland. This article is an open access article distributed under the terms and conditions of the Creative Commons Attribution (CC BY) license (https://creativecommons.org/licenses/by/4.0/).
Share and Cite
Fajdek-Bieda, A.; Pawlińska, J.; Wróblewska, A.; Łuś, A. Evaluation of the Antimicrobial Activity of Geraniol and Selected Geraniol Transformation Products against Gram-Positive Bacteria. Molecules 2024, 29, 950. https://doi.org/10.3390/molecules29050950
Fajdek-Bieda A, Pawlińska J, Wróblewska A, Łuś A. Evaluation of the Antimicrobial Activity of Geraniol and Selected Geraniol Transformation Products against Gram-Positive Bacteria. Molecules. 2024; 29(5):950. https://doi.org/10.3390/molecules29050950
Chicago/Turabian StyleFajdek-Bieda, Anna, Joanna Pawlińska, Agnieszka Wróblewska, and Agnieszka Łuś. 2024. "Evaluation of the Antimicrobial Activity of Geraniol and Selected Geraniol Transformation Products against Gram-Positive Bacteria" Molecules 29, no. 5: 950. https://doi.org/10.3390/molecules29050950
APA StyleFajdek-Bieda, A., Pawlińska, J., Wróblewska, A., & Łuś, A. (2024). Evaluation of the Antimicrobial Activity of Geraniol and Selected Geraniol Transformation Products against Gram-Positive Bacteria. Molecules, 29(5), 950. https://doi.org/10.3390/molecules29050950







